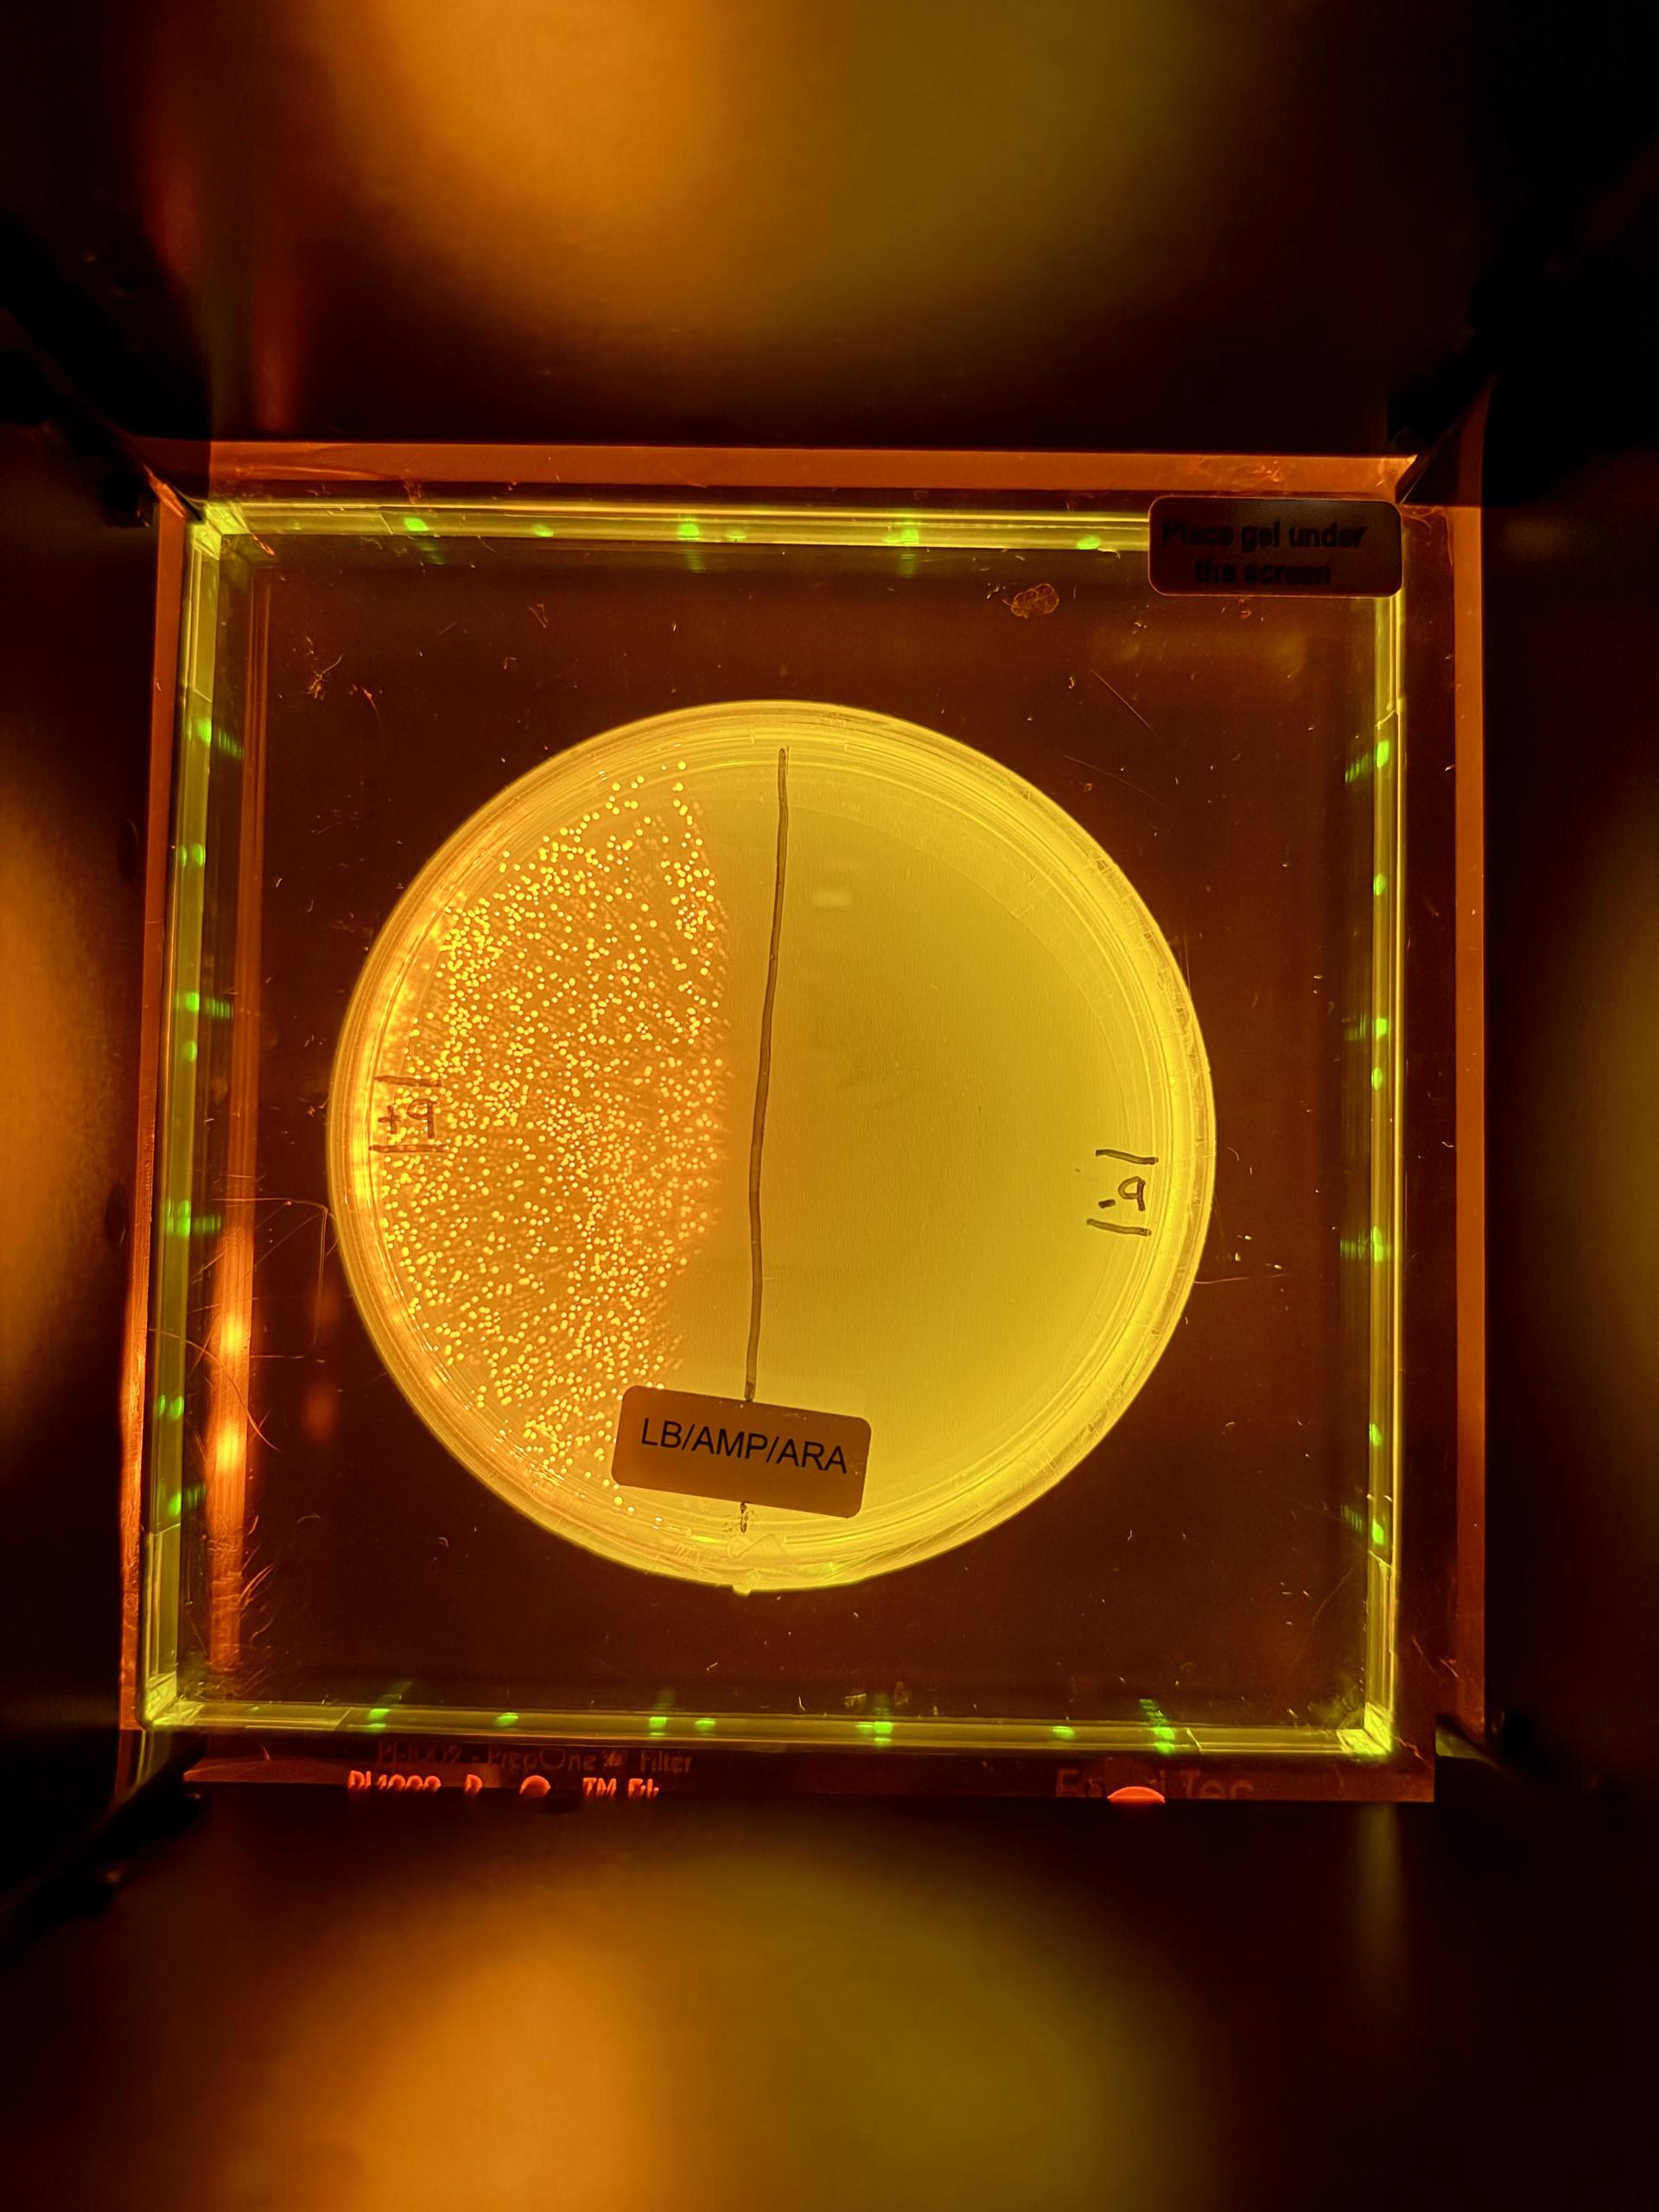

In This Issue
Community Noticeboard
- About our Community Noticeboard
- Welcoming More Young Children to Warrah
- Sydney Rudolf Steiner House - The Story of Michaelmas
- Honest to Goodness Community Buying Group
- Envionmental Art & Design Prize - Northern Beaches 2026
- Jazz at the Lounge - The Concourse 2026
- Staying Connected Fortnightly Group
- Willoughby City Library
The Drum
Imponderables
Imponderables

“You can see from all this that what matters more than anything else in a teacher is the way we regard our holy calling. This is not without significance, for the most important things in teaching and in education are those that are imponderable. A teacher who enters their classroom with this conviction in their heart achieves something different from another.” - Rudolf Steiner, Balance in Teaching, Lecture I
This thought‑provoking reflection, shared by Collegiate Chair Katherine Arconati at a recent K-12 Teacher Meeting, invites us to pause and consider those qualities of education that cannot be measured or quantified, yet are deeply felt and enduring. It speaks powerfully to the inner life of the teacher and to the quiet, purposeful intention with which learning is shaped each day. Reading these words, I am filled with deep gratitude for our teachers, who continue to strive for growth, meaning and purpose in their work, and who hold with care the complex task of nurturing young people of strong character, resilience and heart.
As we enter the final week of term, Steiner’s reminder feels especially timely. At moments of transition and completion, we are afforded the opportunity to step back and recognise the immeasurable work that unfolds across our classrooms, outdoors and across different learning spaces - much of it unseen, yet profoundly significant.
With the term break so close, it might be easy to imagine that activity at Glenaeon is slowing. Nothing could be further from the truth. As I write, final touches of paint and polish are being applied to the set of
Dreamland
, our Year 10 Musical production. Tonight is opening night; the energy is palpable and we greatly look forward to sharing this vibrant production with you. Our Year 12 students are settling into the first nights of their final Outdoor Education experience, a journey that will culminate in 48 hours of solo time in the bush, an impressive and meaningful rite of passage.
At Castlecrag, our Kindergarten and Classes 1 and 2 students are completing their Main Lesson cycles following a magnificent Harvest Festival play for all Primary students, hosted by Class 6. This re‑enactment of the story of St Michael carried a powerful message of inner resolve, initiative and the triumph of light over darkness. Kindergarten students also celebrated Harvest with a shared, full‑day experience apple picking in Bilpin last weekend, a joyful and deeply connected experience of the season. Other classes will experience Harvest Festivals next week.
School concludes for the term holiday and Easter next Wednesday, our final day of lessons for the term. I wish all families a restful and rejuvenating break and look forward to welcoming you back for Term 2.
Diana Drummond
Head of School

Upcoming Glenaeon Events
Glenaeon Musical 2026
Glenaeon Musical 2026
This Wednesday saw the opening night (and Australian premiere) of DREAMLAND , performed by our enthusiastic and talented Year 10 cohort. They performed to a sold out Sylvia Brose Hall filled with excited members of our community there to support our students and the dramatic and musical arts. Our Year 10 students shone on and off stage and a huge thank you to teachers, staff, parent volunteers and the whole community for your support, time and energy. Wishing everyone a big chookas for tonight and tomorrow's sold out performances.
Please enjoy some dress rehearsal snaps below!

Mid-Winter Party – Saturday 13th June Save the Date
Mid-Winter Party – Saturday 13th June Save the Date
YOU'RE INVITED!
The Annual Glenaeon Mid-Winter Party is proudly hosted by the parents of Year 7, and the Silent Auction by the parents of Year 9, on behalf of the Glenaeon Parents Association (GPA).
It is a themed cocktail party for all Glenaeon parents and staff that offers an incredible opportunity to knit together an ever stronger fabric of our wonderful school community each year.
S A V E T H E D A T E !
We can't wait to see you in
A MIDWINTER NIGHT'S DREAM!

School Tours
School Tours
School Tour and Talk - Preschool, Willoughby campus
Date:
Tuesday, 31 March 2026
Time:
11:15am - 12:15pm
Location:
118 Sydney Street, Willoughby NSW 2068
Registration: Book Now

School News
Election of New Directors to the Glenaeon School Board – Letter from the Chair
Election of New Directors to the Glenaeon School Board – Letter from the Chair
Please see a letter from Chair of Glenaeon Board, Peter Candotti on the Election of New Directors to the Glenaeon School Board here .
Primary School Scholarship - Apply Now
Primary School Scholarship - Apply Now
Sylvia Brose All Rounder Scholarship (Foundation Scholarship) For students in Primary School (Kindy – Class 6)
Thanks to the generous support of donors to the Glenaeon Foundation Scholarship Fund, Glenaeon Rudolf Steiner School offers a means-tested scholarship to students who may not otherwise have the opportunity to attend our school.
This scholarship is named in honour of our founder, Ms Sylvia Brose OAM. Recipients reflect the Glenaeon ethos of inspired learning, artistic sensibility, and service to others. They demonstrate well-rounded capabilities and a strong commitment to personal and community growth.
Means Testing
As part of the application process, families are required to submit financial information to determine eligibility. This information will be handled with the strictest confidence and in accordance with the requirements outlined in the application form.
Primary School Entry (Kindergarten – Class 6)
Scholarships for Primary School entry are awarded on the basis of:
- Completed scholarship application form and payment of scholarship application fee of $150
- Successful interview with parents and child
- A commitment to the school’s ethos and Glenaeon’s core values of Integrity, Wisdom, Courage and Heart.
- Two recent school reports
Families with an understanding of Steiner education principles in the Glenaeon context, who also meet the financial eligibility criteria, are strongly encouraged to apply.
Applications for the newly extended Sylvia Brose Scholarships for students in Classes K-6 2027 are now open and will be processed on application.

Holiday Chicken Care
Holiday Chicken Care
Over the holidays, families are warmly invited to spend some time caring for our school chickens at the Middle Cove Garden. This is a lovely opportunity to slow down and connect with the space, whether that’s tending to the flock, spending time weeding, or simply quietly observing the beauty of the surrounding bush. Families can earn CIP points for the time they spend helping care for the chickens.
If you would like to take part, please book a time via SignUp. All information will be provided on the platform once you have signed up. You are also very welcome to join the Chicken Care WhatsApp group for updates and shared care.
Thank you for supporting our school flock. Bolt, Cloudy Jane, Clover, Curio, Eagle and Delta appreciate your attention and care.

Glenaeon Preschool & Playgroups
Term 2 Bookings Now Open
Term 2 Bookings Now Open
Term 2
Playgroups are now open for registrations! For more information and to book, please
Register here
.
We look forward to welcoming you and your little one to Glenaeon Playgroups!
Spaces are limited, so secure your spot today!

Castlecrag News
Kindy Harvest Festival
Kindy Harvest Festival
'Let's leave the city and leave the town
For we are off to visit Cedric's farm...'
Last Sunday Kindergarten gathered together at Cedric's orchard in Bilpin near the Blue Mountains to celebrate Harvest Festival. What a joyous occasion! It was a beautiful day with a touch of Autumn in the air. Farmer Cedric was there as always, greeting everyone and explaining some important aspects of apple picking. We picked apples, sang and danced the songs of our Harvest Circle and then shared food together under the big oak tree. This week, we delighted in making delicious apple crumble in the Kindy classrooms with apples from Farmer Cedric's orchard.










St Michael and the Dragon - Autumn Festival Classes 1 - 6
St Michael and the Dragon - Autumn Festival Classes 1 - 6
The Class 1 to Class 6 Autumn Festival was held on Friday of last week and what a beautiful celebration it was!
A story of St Michael and the Dragon was confidently narrated by Class 6 students, and both year-level and community songs wove the dramatic tableaux seamlessly together. Class 5 students presented the fearful dragon in great style, with writhing, percussion and thunder adding to the dragon’s might, and they depicted the creature’s transformation beautifully as it adhered to Michael’s command and demurely followed the princess to lie at the villagers' feet.
The festival was celebrated just before the autumn equinox, and the St Michael story provided a wonderful image from which the children can draw inner strength during the months to come. As they enter that time of year when nights are longer than days, which can be seen as a metaphor and inwardly lived experience for the threat of the dominance of ‘evil' over ‘good', an image of strength and courage is set before them. Importantly, the dragon is not slain but is instead mastered, indicating our human need not to banish those parts of us that arise from time to time to hinder us (desire for power, shame, fear and the like), but rather to understand their origins with compassion and render their impact ineffectual through inner mastery.
Much gratitude must go to parents of children in Classes 1 and 2 who decorated the hall and prepared the delicious feast of bread and corn. Many thanks are also to be extended to our Class Teachers who readied the children so well, calling forth heartfelt singing and strong voices.










Making, Baking and Donating
Making, Baking and Donating
Castlecrag Campus hosts the Primary Harvest Festival with all children coming up for the Michaelmas festival! After the performance, the children enjoy fresh baked bread rolls and corn prepared by Class 2 children with help from our parent volunteers. There is an early morning crew that starts at 7am to make 10 big bowls of dough for the children to bake nearly 200 bread rolls in the morning! Class 1 parents create the beautiful Harvest display with all the donated food and after the festival the food is collected by Oz Harvest who take it and help prepare food for those in need. Thank you to our wonderful parent volunteers and all the families donating to this wonderful organisation. We love hosting this festival and it's a whole lot of fun getting ready!










Class 1 Gardening and our New Compost!
Class 1 Gardening and our New Compost!
We are so lucky to have our new gardening teacher Kate Flood aka 'Compostable Kate' who has transformed our gardens and developed a wonderful new composting system at Castlecrag! Using large repurposed terracotta pipes, the children have layered compost and carbon together for healthy and dynamic composting! They have also been weeding and transforming the garden beds outside reception and in the beautiful garden outside the staff room! We have an abundance of flowers and bees and bugs which makes for a very happy, growing ecosystem.










Class 3 Explore their Living on Earth Main Lesson
Class 3 Explore their Living on Earth Main Lesson
Class 3 has been exploring their Living on Earth Main Lesson, learning about how people live, work and care for the land. Through the story of a family moving from the city to the country, the children are discovering what it takes to build a farm and become self-sufficient.
Hands-on experiences have been a special part of this learning. The children have made butter, germinated apple seeds and threshed wheat, and will soon spiral apples, grind wheat into flour, bake bread and explore the honey making process.
Through these activities, the children are developing an understanding of how soil, plants, animals and the sun work together, and how human life depends on this balance. This Main Lesson is helping to foster a growing sense of gratitude, responsibility and respect for the natural world and the work involved in sustaining everyday life.










Class 3 Experience Cello and Violin
Class 3 Experience Cello and Violin
Class 3 will start their strings tuition this year, and has the wonderful opportunity to try both instruments with music tutors Cathy Upex and Summer Friedland. The instruments came on a special visit and the children all experienced, playing and exploring the different sounds. Class 3 will learn to read music and play individually and as ensembles this year.







Middle Cove News
High School Autumn Festival
High School Autumn Festival
While the days are still warm and the sun is yet strong enough to entice us to the beach, darker mornings and rainy skies have let us know that the season has changed. We sense that the inwardness of winter will soon be upon us and in our High School Autumn Festival, which will be held on the last day of this term, we will take a little moment to reflect on summer’s gifts and the 'warmth within’ that we can draw on during the coming months (in other words, all that has so far ripened in us as capacities).
Our celebration will weave together both northern hemisphere harvest traditions and First Nations understandings of what is perceivable in early April in our native bushland surrounds. While autumn marks the end of the growth period in the north, the season we experience around us in Sydney is in fact one of growth and returning greenness. In some ways we can interpret these very different natural phenomena as contradictory metaphors, but in both cases the gesture and lived experience is no longer one of expansion and abandon, but is instead one of a settling within. The Cammeraygal name is lost to us, but in the D’harawal* language the season is called Bana Murra’Yung, which means ‘wet coming into cool’.
Bana Murra’Yung will be a strong theme this year, with Year 9 students presenting an improvised percussion piece that starts with pattering rain and Year 12 student, Catina Cocca, performing an evocative composition for the flute that is reminiscent of a still, misty bay. These contributions will be supported by traditional items with which the students are already familiar.
As always, the harvest display will take centre stage and please support your child to bring long-lasting fruit and vegetables on Monday, Tuesdays and Wednesday of next week.
All produce will be donated to Oz Harvest, a Sydney based organisation that provides much needed food for people in need.
*The D'harawal Country and language area extends from the southern shores of Port Jackson (Sydney Harbour) to the northern shores of the Shoalhaven River, and from the eastern shores of the Wollondilly River system to the eastern seaboard (The Bureau of Meteorology, 2020).
The Bureau of Meteorology. (2020). D’harawal calendar | The Bureau of Meteorology. Available here .

Pi Day 2026
Pi Day 2026
Last week we celebrated International Pi (π) Day, which is marked globally on March 14 (3/14). Although Glenaeon celebrated the occasion a little belatedly this year (as it fell on a weekend), it was fantastic to have so many students turn up to our annual Pi recitation event.
The Maths Room was filled with students from Year 7 to Year 12, and it’s great to see such interest in this really important irrational number. In simple terms, π is the ratio of a circle’s circumference to its diameter. It is an irrational number, which means that in decimal form it goes on forever and its digits do not repeat a pattern. No doubt it is this elusive nature of π that fascinates students.
Some of our keenest students put their memory skills to the test, competing to recite as many decimal places as possible. Our reigning champion is Sophia B. (Yr 10), who recited π to an impressive 402 decimal places! Second place went to Raphello M-L. (Yr 10), who recited 129 decimal places, and third place to Dominic S. (Yr 10), with 80 decimal places. Many other students also gave it a go, and we acknowledge their efforts. Remarkably, NASA claims that just 15 decimal places are sufficient for the highest level of accuracy in their calculations, which really puts our students’ feats into perspective!
No competition would be complete without prizes. As with previous years, the awards were canteen vouchers: $31.41 for first place, $6.28 for second place, and $3.14 for third place. Due to inflationary pressures, it is likely that next year the value of the prizes will have to increase, but they will still, of course, be multiples of π!
It was a delight to see such strong participation in this event, and it shows how much our students care about mathematics, and π in particular!



DNA, Genes and Glowing Bacteria: Year 12 Biology Takes on Real-World Biotech
DNA, Genes and Glowing Bacteria: Year 12 Biology Takes on Real-World Biotech
In Week 8 of Term 1, our Year 12 Biology students had an incursion week taking part in the Amgen Biotech Experience (ABE) program in collaboration with The University of Sydney. This international initiative allows students to step into the shoes of real biotechnologists, using research-grade equipment and techniques modelled on those used in biomedical science.
Over the course of the program, students practised precision pipetting and gel electrophoresis, learned how plasmids can be engineered, and applied these tools to create genetically modified bacteria. By adding a recombinant plasmid containing the red fluorescent protein (rfp) gene from a sea anemone into the bacteria E. coli, they were able to produce bacteria that glowed under the blue light.
The class was thoroughly engaged and quickly picked up complex laboratory techniques. Every group successfully completed the experiments, with visible red fluorescent colonies providing clear evidence of genetic modification. These impressive results gave students a deeper appreciation of genetics and demonstrated the power of biotechnology to solve real-world problems.
Students found the experience both fascinating and motivating. The program provided a memorable opportunity to connect classroom learning to real-world applications and has inspired some students to pursue further studies in biotechnology and related fields.

Steiner Boys Climb to Success!
Steiner Boys Climb to Success!
Last weekend Enzo MJ. (Year 10) and Taric S. (Year 9) competed in the Sport Climbing NSW Youth Bouldering Titles at the Sydney Indoor Climbing Gym. It was a thrilling event with 220 young climbers between 11 – 19 years old gathering from NSW and across Australia. Enzo and Taric did us proud - the U17 Males was the biggest event with 56 boys alone. Their preparation and training along with performance and mindset on the day led Enzo to win the event, with Taric coming third. Second place went to Jasper L. from Central Coast Steiner School. Podium placements give the boys automatic selection to represent NSW at the National Bouldering Titles taking place in Ballina in May.




Front Desks
Easter Magic at Grassroots Eco Store
Easter Magic at Grassroots Eco Store
Discover our
Easter Collection
, filled with handmade treasures, including mini wooden rainbow eggs, felt baby bunnies, handmade wooden bilbies, and our colourful Easter treasure baskets made from upcycled saree fabric. Perfect for Easter morning surprises, (chocolate-free) Easter egg hunts, and seasonal displays.
With the school holidays approaching, it is a lovely time to stock up on Autumn and Easter craft supplies, along with our
Nature Craft Activity Books
to keep hands busy and imaginations engaged.
Pop in-store and explore our collection of handwoven
Baskets
, ideal for apple picking, market trips, and Easter treasure hunts!
Opening Hours
Final Week of Term 1, 2026:
Tuesday 31st March :
8:30am—12pm & 2pm—3:45pm
Wednesday 1st April :
8:30am—3:45pm (open all day)
The online store remains open during the school holidays with free local delivery, click & collect or postage options available: grassrootsecostore.com.au
Thank you for supporting local and choosing products that nurture creativity, sustainability, and imagination. A portion of every sale supports Glenaeon.
Grassroots Eco Store is located on the Glenaeon Castlecrag Campus, next to the Marion Mahony Griffin Hall. 121 Edinburgh Road, Castlecrag.

CIP points for Term 1 to be submitted by 1 April
CIP points for Term 1 to be submitted by 1 April
The CIP allocates 32 hours of involvement per year to each family with the option for families to pay a levy in lieu of volunteering at numerous tasks and events. A CIP levy of $160 per term per family is charged up front to school accounts. When voluntary work is done and registered via the CIP service record form , it is credited to their account at the rate of $20 per hour (i.e. 8 hours per term gives you your full credit). You must note your work on the form by the due date (CIP points to be submitted by the deadline, Wednesday 1st April ).
Credits may be accumulated during the calendar year and you don’t have to do the full 8 hours each term for the accumulation to occur. Some families make their entire contribution for the year in a single term by attending a school camp for example. Credits are not carried over from one year to the next.
For families who pay via Direct Debit, your final debit in November will be reduced by any CIP credits that have accumulated during the year (you will receive a statement shortly before showing the amount of your CIP credits).
For families who prepay, you can either elect to leave the credit on your account to offset against the following year’s CIP charges, or if you prefer a refund you can email accounts@glenaeon.nsw.edu.au at the end of the year with your bank account details requesting the refund.
Some of the tasks that attract full CIP credits are class parent, school council member, serving on a committee, running the parent library, and attendance at class camp. Other tasks that may gain CIP credits on an hourly basis include classroom assistance, library support, baking for school events, voluntary work at the preschool, helping with repairs and maintenance, supporting twilight concerts, and assisting in the Biodynamic garden. Note this is not the full extent of activities that will attract CIP credits. If you have a query about the eligibility of a certain task contact the Daily Operations Manager and/or refer to your Parent Handbook.

Glenaeon Parents Association (GPA)
GPA Membership Fees at Work
GPA Membership Fees at Work

The GPA Steering Committee met last week and the room at Castlecrag campus was full of positive energy with all nine committee members present in person.
We covered many topics including review of the GPA budget for 2026, and were pleased to approve continuing the GPA’s long-standing support for the school’s Bursary Fund. The GPA will again contribute $10,000 to the Bursary Fund this year. This follows the GPA Class Benefit Fund new initiative which was announced
in the last newsletter
.
We heard from Diana how important the school’s Bursary Fund is in making it possible for some students to continue at Glenaeon when their families need that support. The GPA has been proudly contributing to this fund for more than 15 years.
Glenaeon Parents Association membership fees of $100 per family per year are processed by the school on the association’s behalf and paid into the GPA bank account annually. Here’s how the total GPA membership fees of approximately $31,000 per year have been put to work in the 2026 budget:
$10,000 allocation to the GPA Class Benefit Fund
$10,000 contribution to the school’s Bursary Fund
$9,000 allocation for operational costs of the GPA as an incorporated association & registered charity, enabling the GPA to fulfil its duties and support community-building & fundraising events & activities each year
$2,000 (approx.) surplus for contribution to the Year 12 graduation (to be supplemented from fundraising proceeds)
The GPA remains in good financial health with substantial cash reserves from fundraising activities (as reported to members each year). This is only possible thanks to the generosity of many parents in giving their time, energy and donations for our Glenaeon community. The Steering Committee looks forward to our next meeting where we’ll consider the school’s requests for contributions from the GPA to special projects in 2026, so these fundraising proceeds can directly benefit students.
To get in touch at any time, please email the GPA Steering Committee at gpa@glenaeon.nsw.edu.au , or ask your Class Parents.
Wishing all Glenaeon families very happy and safe school holidays. Our heartfelt thanks to each of the dedicated parents who have volunteered and contributed in the Glenaeon community this term, acknowledging those taking on bigger roles and others contributing in many ways. See you in Term 2!
Warm regards,
Huw, Alex, Sou, Nick, Matt, Sylvia, Paul, Maja
GPA Steering Committee
GPA Cuppa & Connect
GPA Cuppa & Connect

Alumni
Beniah Visits Glenaeon
Beniah Visits Glenaeon
Glenaeon Alumni, Beniah Brooks recently returned to Glenaeon to connect with her teachers and friends. Since leaving Glenaeon, Beniah went back to Western Australia and her country to reconnect with family. She completed Year 10 in Newman, W.A. She returned to Sydney as a young adult and was practicing her art, holding an exhibition in early 2025. After spending some further time in Western Australia, Beniah is now re-establishing herself in Sydney and enjoying being a mum (she recently welcomed baby Annika who is three months old). She continues to practice her Art and was recently commissioned to create a small mural at Willoughby Uniting Church. We were delighted by Beniah's visit and wish her well in her art and life with her young family.

School Calendar
K - 12 2026 Term Dates
K - 12 2026 Term Dates
2026 Term Dates (K - 12)
Term 1 Thursday 29 January - Wednesday 01 April
Term 2 Wednesday 22 April - Wednesday 01 July
Term 3 Wednesday 22 July - Wednesday 23 September
Term 4 Wednesday 14 October - Wednesday 09 December
All 2026 term dates can be found on GLO. Click here.
2026 Newsletter Publishing Schedule
2026 Newsletter Publishing Schedule
Our Newsletter is published Week 1,3,5,7 and 9 in term time.
Please see our
publishing schedule
for exact dates.
Community Noticeboard
About our Community Noticeboard
About our Community Noticeboard
Welcome to Glenaeon's Community Noticeboard! News items listed in our Community Noticeboard are not school endorsed but are included here for the information and benefit of our wider community. We welcome submissions to appear in this section of our newsletter and inclusion is at the discretion of the Editor. A submission will appear in the newsletter for a maximum of two editions.
Welcoming More Young Children to Warrah
Welcoming More Young Children to Warrah
Warrah Specialist School is pleased to share that we have expanded to include two new Kindergarten to Year 2 classrooms in 2026. This expansion creates opportunities to welcome more students with moderate to severe intellectual disabilities and complex learning needs into a Steiner-informed learning environment.
The early years are such an important foundation, and we are so pleased to be able to extend Steiner education to more young students with additional needs within our community.
We warmly share this news with the Glenaeon community. If you know families seeking a nurturing, specialist setting grounded in Steiner education, we would be grateful if you could help spread the word.
For more information please contact:
Leanne Hall
0498 018 120

Sydney Rudolf Steiner House - The Story of Michaelmas
Sydney Rudolf Steiner House - The Story of Michaelmas

Honest to Goodness Community Buying Group
Honest to Goodness Community Buying Group

Envionmental Art & Design Prize - Northern Beaches 2026
Envionmental Art & Design Prize - Northern Beaches 2026
Entries now open for the 2026 Environmental Art & Design Prize
Artists and designers from across Australia are invited to submit work on the theme of the environment.
This is your chance to showcase your work at our annual exhibition and be part of the conversation shaping our environment in the future.
A $46,000 prize pool is on offer across 4 categories:
- $20,000 Art
- $20,000 Design
- $3,000 Young Artists & Designers (7 to 18 years)
- $3,000 People’s Choice
The year’s esteemed judges are visual artist Laura Jones, and designer and educator Nila Rezaei.
Entries close 18 May.

Jazz at the Lounge - The Concourse 2026
Jazz at the Lounge - The Concourse 2026
Jazz at The Lounge returns for another celebration of Australia’s finest jazz talent, bringing world-class musicians into the intimate setting of The Lounge from March to December. The 2026 season balances legendary artistry with fresh voices, delivering unforgettable nights of rhythm, soul, and spontaneous magic.

Staying Connected Fortnightly Group
Staying Connected Fortnightly Group



